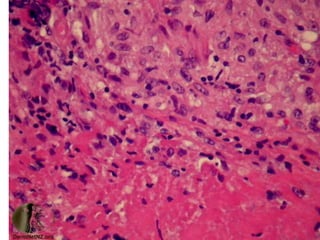
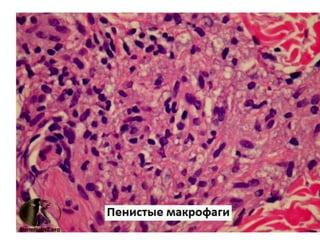

Документ представляет собой презентацию о гранулематозном паттерне дермы, рассматривающую основные виды гранулем, их механизмы образования и гистологические особенности. Гранулемы могут быть вызваны различными заболеваниями кожи, такими как туберкулез, лепра и саркоидоз, каждая из которых имеет свои отличительные признаки и гистологические характеристики. В заключение, документ подчеркивает важность гистологической диагностики для правильного определения типа гранулем и соответствующего лечения.